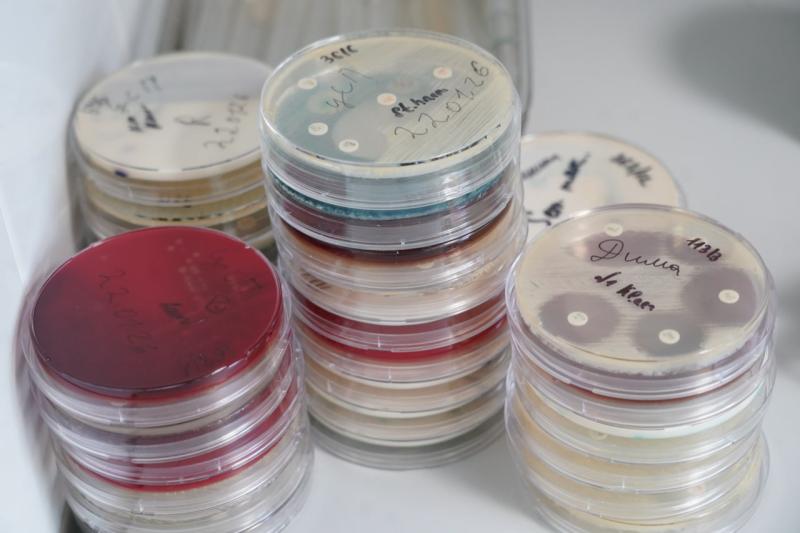
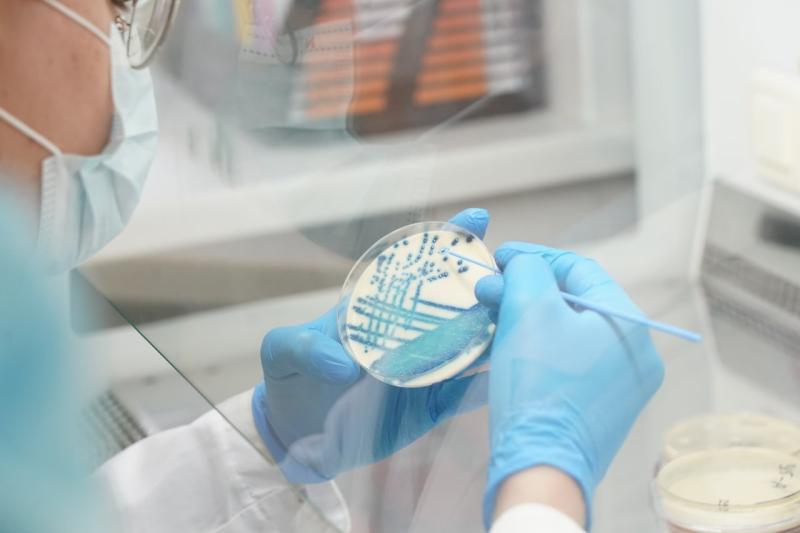

Дмитрий Алексеев учится в университете и является специалистом лаборатории культуромных и протеомных исследований в микробиологии Научно-образовательного профессионального центра генетических и лабораторных технологий вуза. Его исследование поможет людям с хроническим пародонтитом. По словам ученого, сейчас это одно из самых серьезных и социально значимых заболеваний в стоматологии. С помощью разработки стоматологи смогут более точно определять лечение.
- Хронический пародонтит вызывается вредными микробами, которые могут находиться в ротовой полости и о наличии которых клинический специалист может не знать. Многим пациентам имплантаты устанавливают в такой ситуации. В итоге начинается воспаление, - пояснил лаборант.
Алексеев исследовал образцы биоматериала из ротовой полости более 300 больных и участвовал в разработке программы, позволяющей врачам прогнозировать риск развития осложнений у пациентов после установки имплантатов. Ученый пояснил, как это работает:
- Во время осмотра стоматолог берет материал из ротовой полости и отправляет его в микробиологическую лабораторию. Там его исследуют на микроорганизмы. В итоге специалист получает информацию, на основе которой может оценить, какая у пациента микробиота слизистых оболочек – опасная или нормальная. В зависимости от этого он понимает, можно ли ставить пародонтальные имплантаты. Так, например, врач может решить, что пациенту с агрессивной микробиотой есть смысл сначала пролечиться антибиотиками и только потом устанавливать имплантаты.
По словам Алексеева, раньше специалисты принимали такие решения, опираясь только на личный опыт. Соответственно, вероятность сделать ошибку была больше. Ученый же попытался автоматизировать и ускорить процесс определения рисков и выбора терапии.
Алексеев представил исследование на областном конкурсе "Молодой ученый - 2025" (12+) и победил. Программа запатентована и готова к тестированию клиническими специалистами.
Студент Карим Каюмов работает в той же лаборатории. Он усовершенствовал методику выделения микроорганизмов из разных почв. Перечень идентифицируемых "микробов" удалось расширить. Исследование является частью большого проекта в области почвосберегающих технологий. Он учитывает правильные методы посева, работы с землей на микробиологическом уровне. Ученые исследуют микробиоту почв и то, как она влияет на сельскохозяйственную продукцию и в конечном счете на человека.
- Когда мы потребляем продукты животного или растительного происхождения, микробы из почвы попадают в наш организм и могут влиять на здоровье, - сказал Каюмов. - Мы брали образцы почвы с разной глубины и вспаханные разными способами, исследовали их и идентифицировали микроорганизмы, которые полезны или опасны для растений, животных, человека. На основе результатов аграрии смогут подобрать оптимальные условия для посева, что приведет к улучшению качества сельскохозяйственной продукции.
По словам ученого, в процессе исследования выявили много патогенов, которые в теории не должны были находиться в тех или иных почвах.
- Это уже говорит о том, что специалистам из сферы сельского хозяйства стоит пересмотреть условия и методы работы, - добавил Каюмов.
За работу над исследованием ученый получил стипендию Правительства Самарской области.
Молодые ученые отмечают, что научные достижения стали возможны благодаря условиям, которые есть в лаборатории, а денежное поощрение мотивирует работать дальше. Региональное Правительство и лично губернатор Вячеслав Федорищев создают в области все условия для развития молодых исследователей.